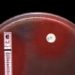
Azithromycin is not associated with increased cardiovascular death in low-risk groups

Image: PD/United States Marine Corps
1. Adult blunt trauma patients treated with high volume crystalloid resuscitation had increased odds of developing acute respiratory distress syndrome, multiple organ failure, surgical site infections, and abdominal compartment syndrome.
2. Increased volume of crystalloid resuscitation was associated with longer time on mechanical ventilation, and longer durations of ICU and hospital length of stays.
Evidence Rating Level: 3 (Fair)
Study Rundown: Aggressive fluid resuscitation techniques have been accepted in early management of trauma for a long time. However, recent studies have shown that large volume crystalloid resuscitation may have adverse outcomes in many trauma populations, including pediatric, burn, and neurosurgical patients. This study demonstrated that increased volume of crystalloid resuscitation within the first 24 hours of injury increased the incidence of highly morbid complications, such as acute respiratory distress syndrome (ARDS), multiple organ failure, surgical site infections, and abdominal compartment syndrome. There was not a significant increase in all-cause mortality. Increased volume resuscitation is also associated with longer time on mechanical ventilation, and longer durations of ICU and hospital length of stays. One limitation of the study is that some baseline characteristics that varied between groups. For example, patients receiving greater volume of resuscitation had higher severity of disease as measured by APACHE-II score and base deficit. The increased volume of resuscitation could be simply reflective of the degree of injury, and may not represent a causative effect.
Click to read the study in The Journal of Trauma and Acute Care Surgery
Relevant Reading: Immediate versus Delayed Fluid Resuscitation for Hypotensive Patients with Penetrating Torso Injuries
In-Depth [retrospective study]: This study examined 1754 blunt trauma patients enrolled over 8 years from the Glue Grant database. Patients were divided into groups based on volume of crystalloids received, from <5 L, 5-10 L, 10-15 L, and >15 L. Baseline characteristics across groups were similar in most aspects, but groups with higher volume of resuscitation had more severe APACHE-II score and base deficit, while groups with lower volume had higher age and comorbidity index.
There was no significant association with volume of crystalloid resuscitation and all-cause mortality, which was the primary endpoint of the study. However, patients who received more than 15 liters of crystalloids in the first 24 hours had three times the odds of developing ARDS, multiple organ failure, or surgical site infection, compared with patients who received less than 5 liters. Patients who received more than 15 liters also had 9 times the odds of developing abdominal compartment syndrome compared to patients who received 5 to 10 liters. Volume of resuscitation was significantly associated with more days on mechanical ventilation (P<0.001), longer ICU stays (P=0.009), and longer hospital stays (P=0.002).
By James Jiang and Allen Ho
© 2013 2minutemedicine.com. All rights reserved. No works may be reproduced without written consent from 2minutemedicine.com. Disclaimer: We present factual information directly from peer reviewed medical journals. No post should be construed as medical advice and is not intended as such by the authors or by 2minutemedicine.com. PLEASE SEE A HEALTHCARE PROVIDER IN YOUR AREA IF YOU SEEK MEDICAL ADVICE OF ANY SORT. Content is produced in accordance with fair use copyrights solely and strictly for the purpose of teaching, news and criticism. No benefit, monetary or otherwise, is realized by any participants or the owner of this domain.